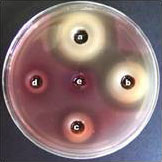
P. Acnes
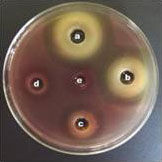
抗菌药物耐性 P. acnes菌
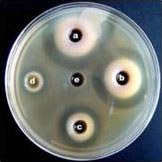
S. aures 菌

Bee Venom 蜂毒取自活蜜蜂毒囊。一只蜜蜂大约一次释放 0.3mg蜂毒。为了获取 1g蜂毒 ,需要数千只蜜蜂。
蜂毒因使用专利技术蜂毒提取器,不杀死蜜蜂,只提取毒液而极为环保。
本产品通过一系列提炼过程,是可适用于皮肤的化妆品功能性原料。
形成粉刺的主要细菌是痤疮丙酸杆菌(P.acnes)及金黄色葡萄球菌(S.aures)。因此,通过抗菌、消炎来抑制细菌繁衍与生殖是管理粉刺皮肤的第一步也是最为重要的部分。
神蜂精占蜂毒成分中的 50-60%,具有出色的消炎及抗菌功能,有效抑制导致皮肤过敏的细菌生长,有助于治疗粉刺皮肤。
另外,还促进血液循环,帮助皮肤细胞的再生。
消炎及抗菌效果

根据蜂毒浓度的抗菌效果
a,b,c,d, e: 0, 1, 2.5, 5, 10 mg 蜂毒
针对主要皮肤常住菌,蜂毒的优秀抑制生长功效得到认可
肽(Peptides) : 蜂毒干重量的主要成分中占 50-60%
蜂毒肽(Melittin)、 蜂毒明肽 (Apamin)、蛋白酶抑制剂(Protease Inhibitor)
肥大细胞脱颗粒(Mast Cell Degranulation Peptide)、神蜂精(Secarpin)、 托肽品(Tertiapin)、 普鲁卡因(Procamine)

产品名 : Neocare 蜂毒 (Neocare Bee Venom)
INCI 名: 蜂毒 (Bee Venom)
| 分析检查 | 具体事项 |
|---|---|
| 外形 | 浅黄色粉末 |
| 芳香 | 淡香 |
| 蜂毒 | ≥ 99.9% |
| 神蜂精 | ≥ 60% |
| pH | 4.0~7.5 in water (10ppm) |
| Pb | ≤ 10ppm |
| 砷 | ≤ 2ppm |
| INCI 名 | 结构比率 |
| Beevenom | ≥ 99.9% |
产品名 : Neocare 蜂毒 500PH (Neocare Bee Venom 500PH)
INCI 名: 蜂毒 / 1,3 丙二醇 / 1,2 己二醇
| Analytical Test | 具体事项 |
|---|---|
| 外形 | 透明液体 |
| 芳香 | 淡香 |
| 蜂毒 | ≥ 500ppm |
| 神蜂精 | ≥ 300ppm |
| pH | 4.0~6.0 |
| Pb | ≤ 10ppm |
| 砷 | ≤ 2ppm |
| INCI 名 | 结构比率 |
| 蜂毒 | 500ppm |
| 1,3 丙二醇 | 30% |
| 1,2 己二醇/td> | 5% |